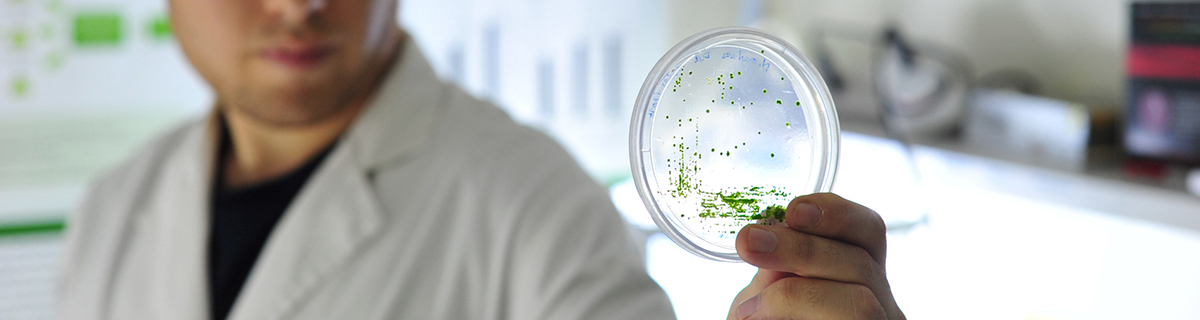

Austral Biotech
Austral Biotech es un equipo multidisciplinario, compuesto por técnicos, profesionales y doctores, todos los cuales complementamos el trabajo netamente científico con labores de asesoría, implementación y gestión de proyectos de I+D. Contamos con infraestructura moderna y completa, con laboratorios en el área de biología molecular y química y de biocultivo.